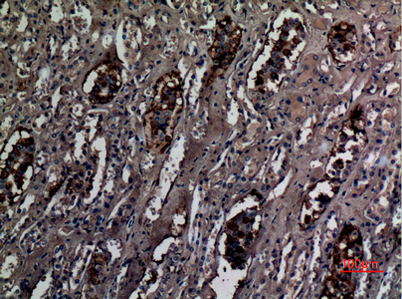

$148.00/50µL $248.00/100µL
| 50 µL | $148.00 |
| 100 µL | $248.00 |
| Product name: | RhCG rabbit pAb |
| Reactivity: | Human;Rat;Mouse; |
| Alternative Names: | RHCG; C15orf6; CDRC2; PDRC2; RHGK; Ammonium transporter Rh type C; Rh glycoprotein kidney; Rhesus blood group family type C glycoprotein; Rh family type C glycoprotein; Rh type C glycoprotein; Tumor-related protein DRC2 |
| Source: | Rabbit |
| Dilutions: | Western Blot: 1/500 - 1/2000. IHC-p: 1:100-300 ELISA: 1/40000. Not yet tested in other applications. |
| Immunogen: | Synthesized peptide derived from the Internal region of human RhCG. |
| Storage: | -20°C/1 year |
| Clonality: | Polyclonal |
| Isotype: | IgG |
| Concentration: | 1 mg/ml |
| Observed Band: | 53kD |
| GeneID: | 51458 |
| Human Swiss-Prot No: | Q9UBD6 |
| Cellular localization: | Apical cell membrane ; Multi-pass membrane protein . Also detected at the basolateral membrane and in subapical vesicles. . |
| Background: | developmental stage:Specifically expressed in fetal kidney.,function:Functions as an electroneutral and bidirectional ammonium transporter. May regulate transepithelial ammonia secretion.,PTM:N-glycosylated.,similarity:Belongs to the ammonium transporter (TC 2.A.49) family. Rh subfamily.,subcellular location:Also detected at the basolateral membrane and in subapical vesicles.,tissue specificity:Expressed in brain, testis, placenta, pancreas, esophagus and prostate. Expressed in squamous epithelial tissues (at protein level). Specifically expressed in kidney according to PubMed:11062476., |